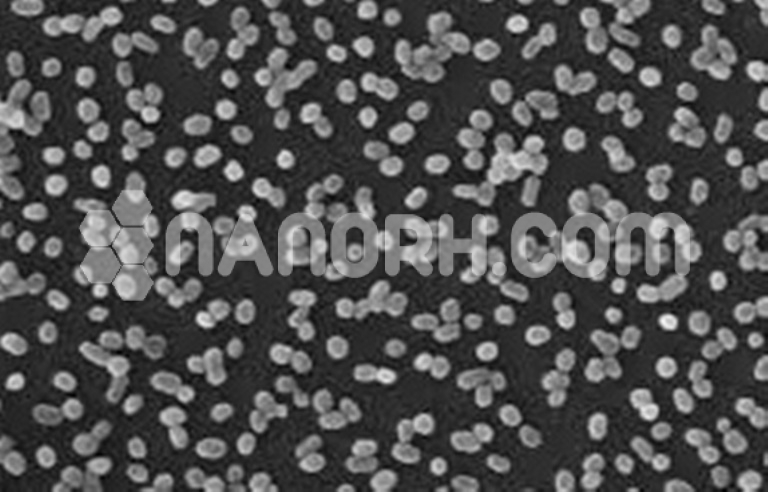
Barium Titanate (BaTiO3) MicroPowder Barium Titanate (BaTiO3) MicroPowder

Barium Titanate (BaTiO3) MicroPowder, BaTiO3
High-density optical data storage; Phase conjugated mirrors and lasers;
Nonlinear optical devices; Pattern recognition; Micro-capacitors; Ferroelectric ceramics;
PTC thermistors; On-chip programmable devices; Optical computing; Optical image processing; Piezoelectric devices; Pyroelectric sensors…………
| Barium Titanate MicroPowder | |
| Product Number | NRE-10007 |
| CAS No. | 12047-27-7 |
| Formula | BaTiO3 |
| Molecular Weight | 233.19g/mol |
| APS | <40 µm (Can be Customized) |
| Purity | 99.9% |
| Colour | white |
| Density | 6.02 g/cm3 |
| Melting Point | 1625 °C |
| Boiling Point | NA |
Barium Titanate MicroPowder
Barium titanate is an inorganic compound with the chemical formula BaTiO3. Barium titanate appears white as a powder and is transparent if prepared as large crystals. It is a ferroelectric ceramic material with a photorefractive effect and piezoelectric properties. It is used in capacitors, electromechanical transducers, and non-linear optics. Barium titanate is a dielectric ceramic used in capacitors, with dielectric constant values up to 7,000. In a restricted temperature range, values up to 15,000 are possible; the most common ceramic and polymeric materials are less than 10, while others, such as titanium dioxide (TiO2), have values between 20 and 70.
It is a piezoelectric material used in microphones and other transducers. Spontaneous polarization of individual barium titanate crystals at room temperature varies between 0.15 C / m 2 in the previous studies and 0.26 C / m 2 in the most recent publications, and their Curie temperature is between 120 and 130 ° C The differences are related to the growth technique, since crystals grown in a previous flow are less pure than the current ones with the Czochralski process, which therefore have a wider spontaneous polarization and a higher Curie temperature.
As a piezoelectric material, it has been largely replaced by lead zirconate titanate, also known as PZT. Polycrystalline barium titanate has a positive resistance temperature coefficient, which makes it a useful material for thermistors and self-regulating electric heating systems.
The barium titanate crystals are used in non-linear optics. The material has a coupling gain between the high beams and can be used at near-visible and infrared wavelengths. It has the highest reflectivity of the materials used for self-pumped phase conjugation applications (SPPC). It can be used for continuous mixing of four waves with the optical power of the milliwatt range. For photorefraction applications, barium titanate can be doped with other elements, e.g. board.